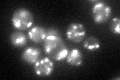
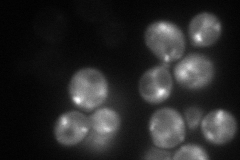
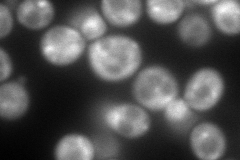
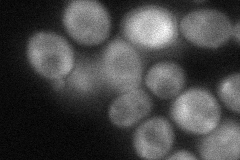
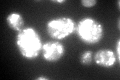

View description
Golgi-localized protein with homology to gamma-adaptin, interacts with and regulates Arf1p and Arf2p in a GTP-dependent manner in order to facilitate traffic through the late Golgi
Localization:
Intensity:
Fold change:
Significance:
-
C’ GFP library in SD
punctate73.83 -
N' NOP1pr-GFP in SD
punctate18.524 -
N' TEF2pr-mCherry in SD
cytosol,punctate237.249 -
N' NATIVEpr-GFP in SD

punctate48.6775 -
N' TEF2pr-VC and Cyto-VN in SD
cytosol47.4348 -
C’ GFP library in SD+DTT
punctate80.751.09No -
C’ GFP library in SD+H2O2

punctate76.581.03No -
C’ GFP library in Starvation Media

punctate64.780.87No -
C’ GFP library on the background of Pup2-DaMP

punctate -
C’ GFP library on the background of CCT mutant

punctate81.36651.10191No
